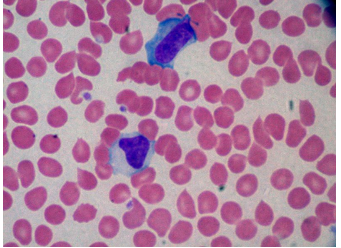

Hx pf antimalarial drug ==> fatigue, dark urine, jaundice/icterus ==> Dx?
Sources of oxidative stress ==> hemolytic anemia in G6PD deficient individuals
Presentation of G6PD deficiency
Zidovudine: MOA, use
-“navir” drugs MOA
usually viral protease inhibitors
Dx?
hepatocellular carcinoma
Common form of spread/metastasis of hepatocellular carcinoma
Cancers that spread via hematogenous dissemination + common sites of metastasis
Renal presentation in goodpasture sydnrome

Most common cause of infectious mononucleosis
Common finding on peripheral smear of individual with EBV
Presentation of aortic stenosis
Most common cause of aortic stenosis
Toxoid definition
Presentation of tumor lysis syndrome
Major risk factors for hepatocellular carcinoma
Possible rare cause of hepatocellular carcinoma in patients from outside US
Major histologic feature in Niemann-Pick disease
Common building block for fatty acids
malonyl-CoA (3 carbon unit)
Common cause of osteomylitis in IV drug users
Tx of Pseudomonas aeruginosa
EBV mechanism + presentation
Lead poisoning: affected enzyme and accumulated substrate
Mechanism of aortic dissection in Marfan’s syndrome